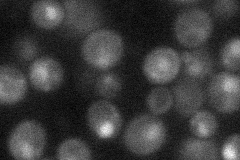

View description
Member of the Sir2 family of NAD(+)-dependent protein deacetylases; involved along with Hst4p in telomeric silencing, cell cycle progression, radiation resistance, genomic stability and short-chain fatty acid metabolism
Localization:
Intensity:
Fold change:
Significance:
-
C’ GFP library in SD

nucleus17.45 -
N' NOP1pr-GFP in SD
cytosol,nucleus30.0603 -
N' TEF2pr-mCherry in SD

below threshold5.85609 -
N' NATIVEpr-GFP in SD

nucleus22.1248 -
N' TEF2pr-VC and Cyto-VN in SD

#N/A0 -
C’ GFP library in SD+DTT

nucleus17.130.98No -
C’ GFP library in SD+H2O2

nucleus16.380.93No -
C’ GFP library in Starvation Media

nucleus14.070.8No -
C’ GFP library on the background of Pup2-DaMP

nucleus -
C’ GFP library on the background of CCT mutant

nucleus19.80481.13442No
